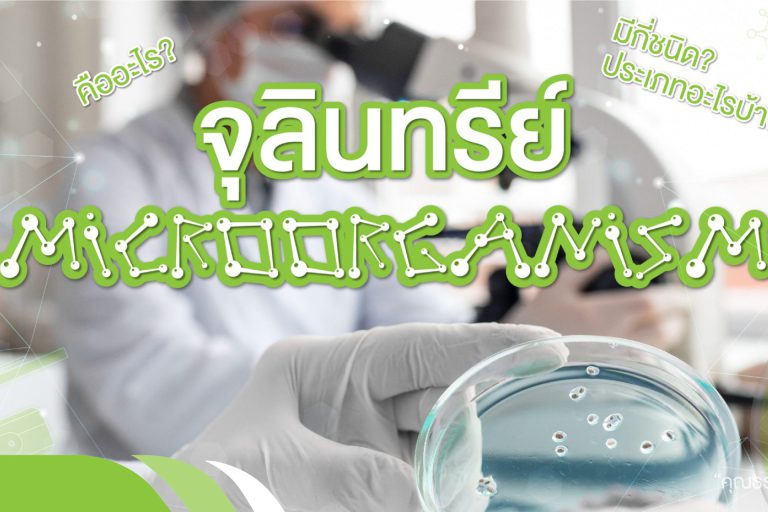

น้ำส้มควันไม้ หรือ น้ำวู้ดเวเนการ์ ( Wood Vinegar )
น้ำส้มควันไม้เป็นของเหลวสีน้ำตาลใสมีกลิ่นควันไฟ ได้มาจากการควบแน่นของควันที่เกิดจากการผลิตถ่านไม้ในช่วงที่ไม้กำลังเปลี่ยนเป็นถ่าน ในช่วงที่อุณหภูมิในเตาอยู่ระหว่าง 300 – 400 องศาเซลเซียส สารประกอบต่างๆ ในไม้ฟืนจะถูกสลายตัวด้วยความร้อนเกิดเป็นสารประกอบใหม่มากมาย…